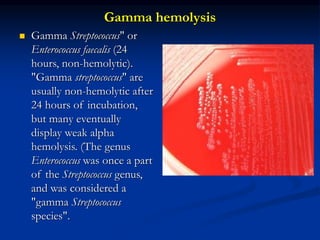

4 blood agar and hemolysis and mac-conkey.ppt
Por um escritor misterioso
Last updated 24 março 2025


4 blood agar and hemolysis and mac-conkey.ppt

Differences Between Staphylococcus and Streptococcus - Microbiology Info.com

Selective and Differential Media - ppt download
Differential Selective Bacterial Growth Media Microbiology Lecture Powerpoint VMC, PDF, Streptococcus

Hemolysis (microbiology) - Wikipedia

Differential & Selective Media, Definition & Examples - Video & Lesson Transcript

Microbiology Lab Final Flashcards

4 blood agar and hemolysis and mac-conkey.ppt

Practical No.17 Proteus & Pseudomonas. - ppt download
4 blood agar and hemolysis and mac-conkey.ppt

4 blood agar and hemolysis and mac-conkey.ppt

PPT - practice test questions review questions study guides and learning objectives PowerPoint Presentation - ID:6728684
Recomendado para você
-
Veja os requisitos para jogar The Medium no PC - Mão de Vaca Descontos - Cashback, Cupons e Promoções24 março 2025
-
Layers of Fear: veja lançamento, gameplay e requisitos do jogo de terror24 março 2025
-
The Medium on Steam24 março 2025
-
The Medium: confira os requisitos mínimos e recomendados24 março 2025
-
The Medium, Software24 março 2025
-
The Medium revela los requisitos completos para la versión de PC24 março 2025
-
Bloober Team detalla el peso y los requisitos para jugar The Medium en PC24 março 2025
-
The Midnight Hour - Atlantic '41 by StephanRewind24 março 2025
-
Game Design Merit Badge Presentation24 março 2025
-
Medi-Temp Reusable Hot&Cold Compress Medium Universal 1ct24 março 2025
você pode gostar
-
MHW: ICEBORNE All Trophy & Achievement List - GameWith24 março 2025
-
Conheçam o elenco do novo filme Mortal Kombat 224 março 2025
-
Harder Mecha Sonic [Sonic 3 A.I.R.] [Mods]24 março 2025
-
Sudoku Puzzles by Puzzle Baron24 março 2025
-
zangadinho on X: queria saber se o T3ddy tá em oferta24 março 2025
-
3D file mera mera no mi one piece ♠️・3D printer design to download・Cults24 março 2025
-
🌍🍭QUIZ Conhecimentos Gerais - Dia Das Crianças #LecoQuiz24 março 2025
-
Butler's buzzer-beater sends San Diego State to title game24 março 2025
-
Fake GTA 6 Rating Sparks Reveal and Release Date Rumors24 março 2025
-
Pin em Atividades24 março 2025